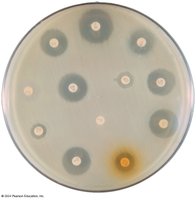
Disk-Diffusion Method for Determining Activity of Antimicrobials

BackChemotherapeutic Agents and Antimicrobial Drugs: Mechanisms, Classes, and Resistance
Study Guide - Smart Notes
Tailored notes based on your materials, expanded with key definitions, examples, and context.
Chemotherapeutic Agents
The History of Chemotherapy
Chemotherapy is a cornerstone of modern microbiology, focusing on the use of drugs to treat diseases caused by microorganisms. Two key contributors to this field are Paul Ehrlich, who pioneered the concept of selective toxicity, and Alexander Fleming, who discovered penicillin, the first true antibiotic.
Terminology and Classification
Chemotherapy: The use of drugs to treat disease.
Antimicrobial drugs: Compounds that interfere with the growth of microbes within a host.
Antibiotic: A substance produced by a microbe (usually a fungus or bacterium) that inhibits another microbe.
Selective toxicity: The ability of a drug to kill harmful microbes without damaging the host.
Paul Ehrlich- "magic bullet" that would selectively find and destroy pathogens but not harm the host.
Alexander Flemming- discovered penicillin
Types of Antimicrobial Agents
Antibacterial
Antifungal
Antiprotozoan
Antiviral
Source of Compounds
Natural: Produced by bacteria or fungi (e.g., penicillin, cephalosporins).
Semisynthetic: Chemically modified natural agents (e.g., ampicillin, methicillin).
Synthetic: Man-made compounds (e.g., sulfonamides, trimethoprim).
Dosage and Toxicity
Therapeutic dose: The dose needed to cure the disease.
Toxic dose: The dose that produces adverse effects in the patient.
Therapeutic index: Ratio of toxic dose to therapeutic dose. A higher index indicates greater safety.
Spectrum of Antimicrobial Activity
Narrow spectrum: Drugs that affect a limited range of microbes. ex. Penicillin G
Broad spectrum: Drugs that affect a wide range of gram-positive or gram-negative bacteria.
Superinfection: Overgrowth of normal microbiota resistant to antibiotics (e.g., Candida albicans, Clostridioides difficile).
Action Modes of Antimicrobial Drugs
Overview of Mechanisms
Antimicrobial drugs act through several distinct mechanisms to inhibit or kill microbes. The five major modes of action are:
Inhibition of cell wall synthesis (e.g., penicillins, cephalosporins, bacitracin, vancomycin)
Inhibition of protein synthesis (e.g., chloramphenicol, erythromycin, tetracyclines, streptomycin)
Inhibition of nucleic acid replication and transcription (e.g., quinolones, rifampin)
Inhibition of essential metabolite synthesis (e.g., sulfanilamide, trimethoprim)
Injury to plasma membrane (e.g., polymyxin B)

Inhibition of Cell Wall Synthesis
Penicillins: Prevent synthesis of peptidoglycan, especially effective against gram-positive bacteria.
Cephalosporins: Similar mechanism to penicillins; grouped by generation.
Bacitracin: Topical application; works against gram-positives.
Vancomycin: Last line against antibiotic-resistant MRSA.
Teixobactin: Effective against resistant gram-positives.
Antimycobacterial antibiotics: Isoniazid and ethambutol inhibit mycolic acid synthesis in mycobacteria.
Penicillin and Cephalosporin Structure Comparison
Both penicillins and cephalosporins contain a β-lactam ring, which is crucial for their activity. The chemical side chains and ring structure differ, affecting their spectrum and resistance profiles.

Inhibition of Protein Synthesis
Chloramphenicol: Inhibits peptide bond formation; binds to 50S subunit.
Aminoglycosides: Change shape of 30S subunit; can cause auditory and kidney damage.
Tetracyclines: Interfere with tRNA attachment; broad spectrum; risk of superinfection.
Pleuromutilins: Topical, effective against gram-positives.
Macrolides: Macrocyclic lactone ring; narrow spectrum against gram-positives.
Injury to Plasma Membrane
Lipopeptides (Daptomycin): Attacks bacterial cell membrane; used for skin infections.
Polymyxin B: Topical; effective against gram-negatives; combined in ointments.
Polymyxin E (colistin): Effective against gram-negatives.
Inhibition of Nucleic Acid Synthesis
Rifamycin (rifampin): Inhibits mRNA synthesis; antitubercular activity.
Quinolones and Fluoroquinolones: Inhibit DNA gyrase; broad spectrum; risk of tendon rupture.
Inhibition of Essential Metabolite Synthesis
Sulfonamides: Inhibit folic acid synthesis; structurally similar to PABA.
Trimethoprim: Inhibits conversion of dihydrofolic acid to tetrahydrofolic acid.
Drug synergism: Combination of trimethoprim and sulfamethoxazole (TMP-SMZ).
Antifungal, Antiviral, Antiprotozoan, and Antihelminthic Drugs
Antifungal Drugs
Agents affecting fungal sterols: Polyenes (nystatin, amphotericin B), azoles, allylamines.
Griseofulvin: Inhibits microtubule formation; active against dermatophytes.
Tolnaftate: For athlete’s foot.
Pentamidine: Anti-Pneumocystis; may bind to DNA.
Antiviral Drugs
Entry and fusion inhibitors: Block virus binding and fusion.
Uncoating, genome integration, and nucleic acid synthesis inhibitors: Prevent viral replication.
Protease inhibitors: Example: Paxlovid® for COVID-19.
Interferons: Produced by infected cells to inhibit viral spread.
Antiretrovirals: Used to treat HIV/AIDS.
Antiprotozoan Drugs
Quinine and chloroquine: Treat malaria.
Artemisinin: Kills Plasmodium species.
Metronidazole, Tinidazole, Nitazoxanide: Treats Trichomonas, giardiasis, amebic dysentery.
Miltefosine: Treats amebic encephalitis and leishmaniasis.
Antihelminthic Drugs
Niclosamide: Prevents ATP production; treats tapeworms.
Praziquantel: Alters membrane permeability; treats tapeworms and flukes.
Mebendazole and albendazole: Interfere with nutrient absorption; treat intestinal helminths.
Ivermectin: Causes paralysis; treats roundworms and mites.
Tests to Guide Chemotherapy
Diffusion Methods
The disk-diffusion method (Kirby-Bauer test) is used to determine the effectiveness of chemotherapeutic agents. Paper disks containing drugs are placed on agar inoculated with the test organism. The zone of inhibition around each disk indicates the sensitivity of the organism to the antibiotic.
Resistance to Antimicrobial Drugs
Mechanisms of Resistance
Persister cells: Microbes with genetic traits allowing survival during antibiotic exposure.
Superbugs: Bacteria resistant to many antibiotics.
Resistance genes: Spread horizontally via plasmids or transposons.
Common resistant pathogens: Acinetobacter baumannii, Pseudomonas aeruginosa, Enterobacteriaceae.
Mechanisms
Enzymatic destruction or inactivation of the drug
Prevention of penetration to the target site
Alteration of the drug’s target site
Rapid efflux (ejection) of the antibiotic
Cost and Prevention of Resistance
Higher rates of disease and mortality
New drug development is costly
Finish prescriptions; avoid misuse
Healthcare workers should avoid unnecessary prescriptions and use narrow spectrum antibiotics
Antibiotic Misuse
Misuse selects for resistance mutants
Includes: using antibiotics without prescription, outdated drugs, inappropriate conditions, animal feed, incomplete regimens, leftover prescriptions
Effects of Drug Combinations
Synergism: Effect of two drugs together is greater than either alone.
Antagonism: Effect of two drugs together is less than either alone.
Summary Table: Major Classes of Antimicrobial Drugs
Class | Mode of Action | Examples |
|---|---|---|
Cell Wall Synthesis Inhibitors | Inhibit peptidoglycan synthesis | Penicillins, cephalosporins, vancomycin |
Protein Synthesis Inhibitors | Target 70S ribosomes | Chloramphenicol, tetracyclines, aminoglycosides |
Membrane Injury | Disrupt membrane integrity | Polymyxin B, daptomycin |
Nucleic Acid Synthesis Inhibitors | Block DNA/RNA synthesis | Quinolones, rifampin |
Metabolite Synthesis Inhibitors | Block folic acid pathway | Sulfonamides, trimethoprim |
Key Equations
Therapeutic Index:
Additional info: Academic context was added to clarify mechanisms, drug classes, and resistance, and to ensure completeness for exam preparation.